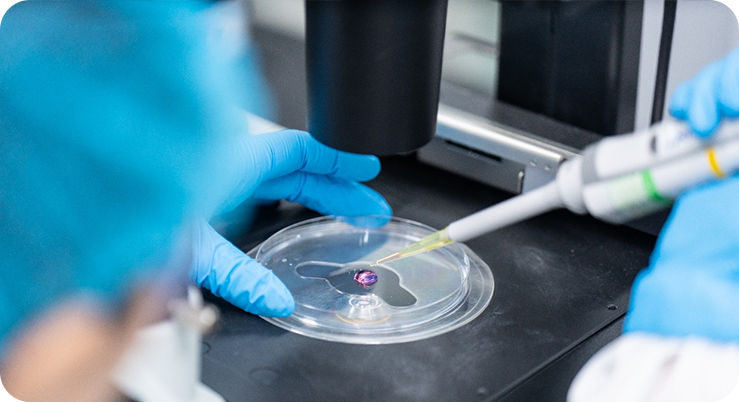

健顺生物始终以提供高质量产品与服务为核心,构建了全面且严苛的质量管理体系。体系以多重权威认证与合规备案为基础:通过 ISO 13485、ISO 9001、ISO 14001、ISO 45001、FSSC22000 及 HALAL 等国际国内认证,2015 年完成细胞培养基一类医疗器械备案,部分产品亦在美国 FDA 完成 DMF 备案,从资质层面奠定质量保障基石。
在具体实践中,公司严格遵循 ISO 13485 与 ISO 9001 标准,以 GMP(良好生产规范)为生产与质量控制的核心原则,尤其参考针对活性药物成分(API)的 ICH Q7 指南,并融合中国 GMP 规定,确保产品既符合国际标准,又适配本土法规要求。同时,通过对标中国药典、国际制药工程协会(ISPE)最佳实践及世界卫生组织(WHO)指导原则,持续提升全流程的国际化与标准化水平。
综上,健顺生物通过整合 ISO 系列标准、GMP、ICH Q7、中国 GMP、中国药典、ISPE 及 WHO 等多重权威要求,形成覆盖研发至商业化生产全环节的质量管理体系,以最高标准保障产品质量与公众健康安全。